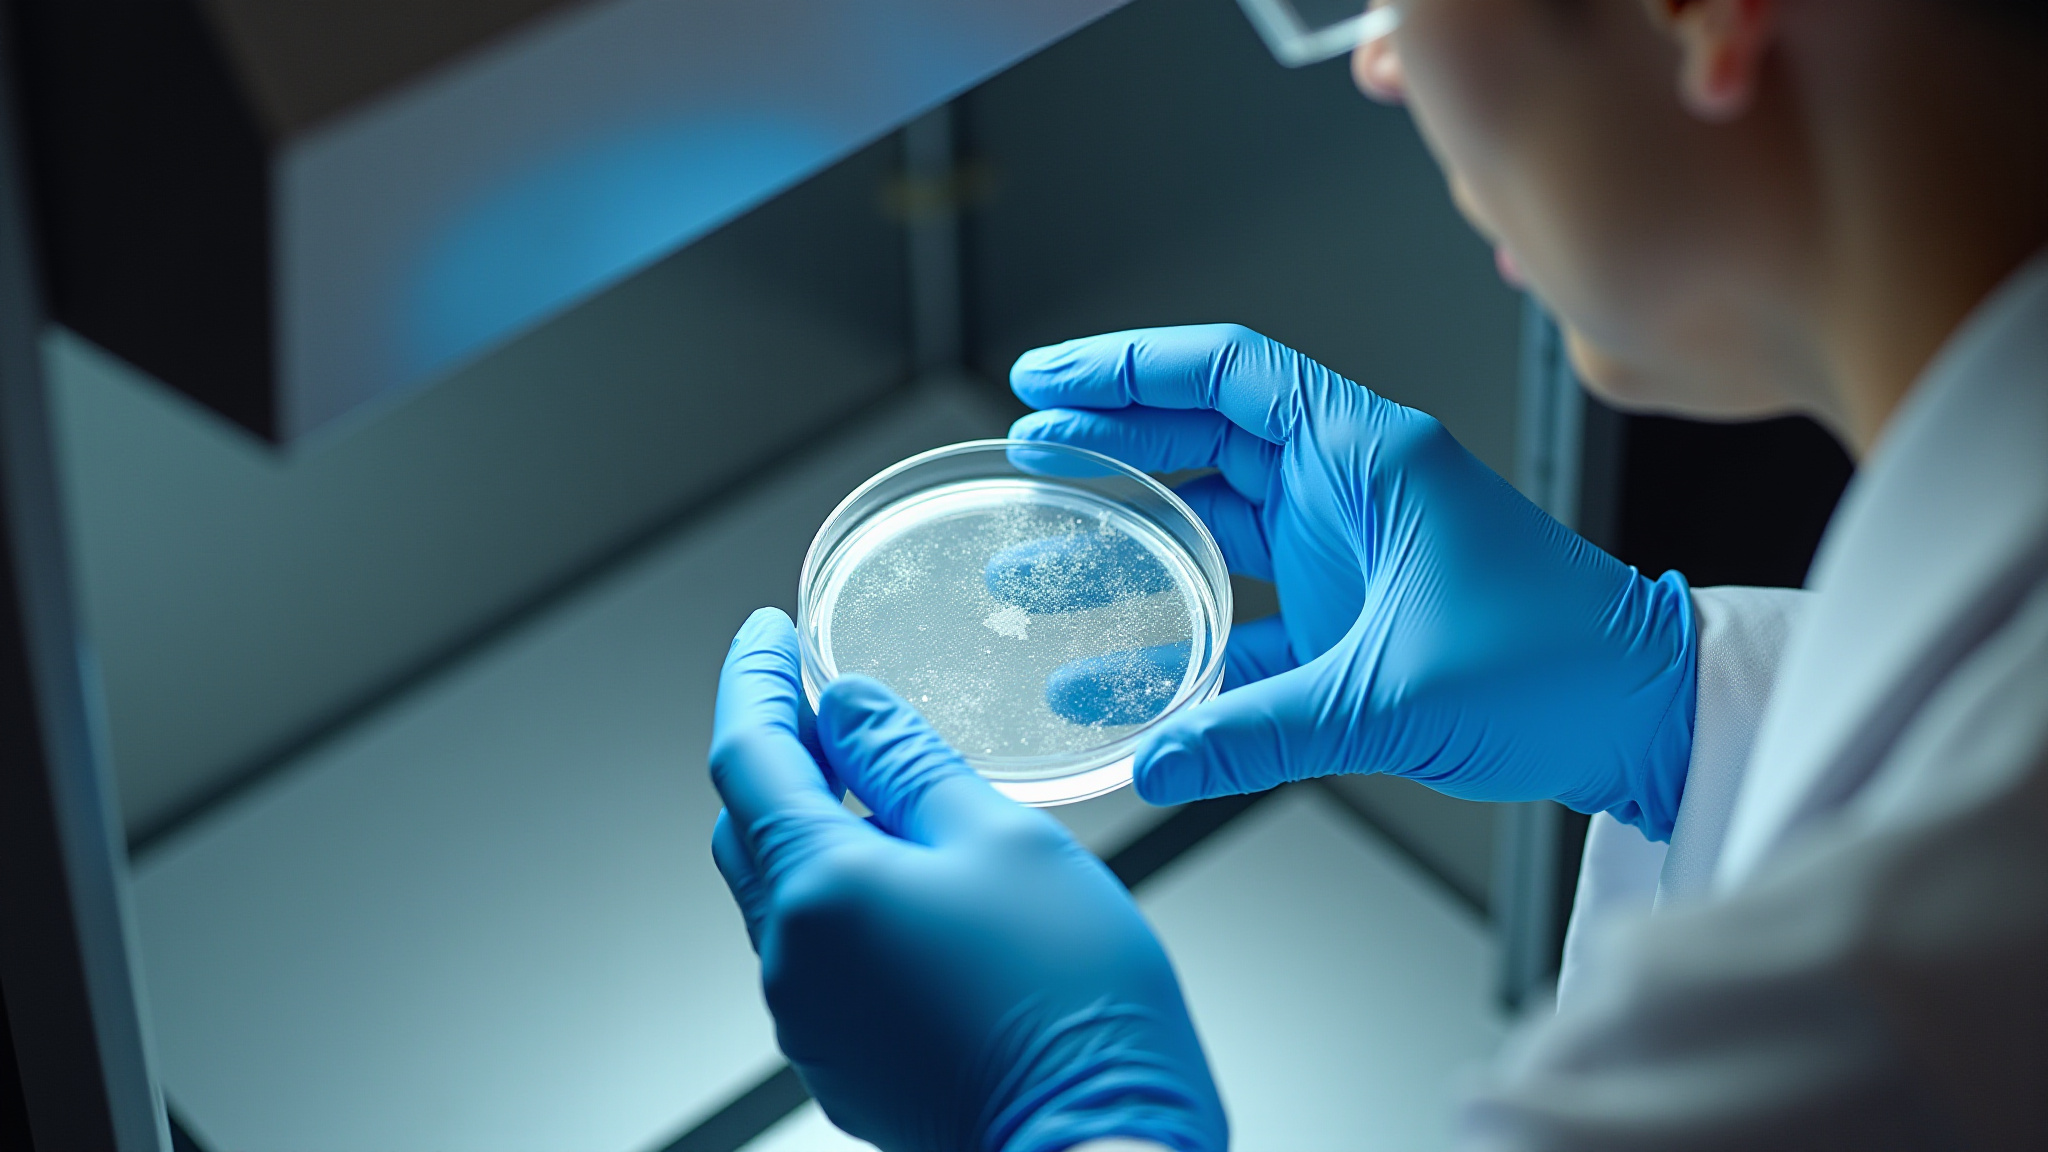

Redefining Gene Editing CRO service
Enhance the speed, quality and scale of your drug discovery research with our cutting-edge gene editing solutions.

About Us
%20(2).jpg)

Our Mission and Vision
At Prime.io, we revolutionize cell line engineering in early drug discovery. Our cutting-edge CasN technology ensures high knock-in editing efficiency, delivering faster and superior services. We are a group of dedicated genetic engineers who wish to accelerate your drug discovery research. We wish to help you validate your drug targets and move to clinical study as quick as possible.
Meet the team
Founder and CEO

Dr. Rex Li is a gene editing specialist with 10 years experience in CRISPR screening and engineered cell model development. He completed a postdoc at the University of Cambridge’s Milner Therapeutics Institute (2022–2025), where he led genome-wide CRISPR-Cas9 drug resistance/sensitivity screens in cancer models and helped build arrayed CRISPRi platforms for high-throughput validation. He earned his PhD at King’s College London (2018–2022), developing iPSC-derived hepatocyte disease models and generating isogenic edited clones via RNP electroporation and genotyping. He previously joined two world's leading accelerator 50 years USA and Entrepreneur First UK.
Advisor


Dr. Nikhil Gupta is a Principal Scientist at Cancer Research Horizons–Cancer Research UK, based at the AstraZeneca Functional Genomics Centre in Cambridge. He has over 18 years of experience in functional genomics, CRISPR technologies, epigenetics, stem cell biology, and cancer research, with a focus on identifying genetic dependencies and resistance mechanisms relevant to cancer therapeutics. He earned his PhD in Chromatin Biology and Epigenetics in India, followed by postdoctoral training in the United States and France. Dr. Gupta has published in high-impact journals including Nature Structural & Molecular Biology, Nucleic Acids Research, and Oncogene, and currently leads the development of advanced CRISPR screening platforms integrating genome engineering with translational cancer research.
Sir Tony Kouzarides is an esteemed academic and entrepreneur well known for his major role in the success of the Cambridge life sciences ecosystem, including co-founding both the Milner Therapeutics Institute and Abcam.
Tony has significant experience in founding and growing therapeutics companies, including as co-founder and ex-director of Chroma Therapeutics, co-founder and director of STORM Therapeutics, and co-founder and CEO of Vellos. In addition to these roles, Tony is a Venture Partner at Fifty Years.
